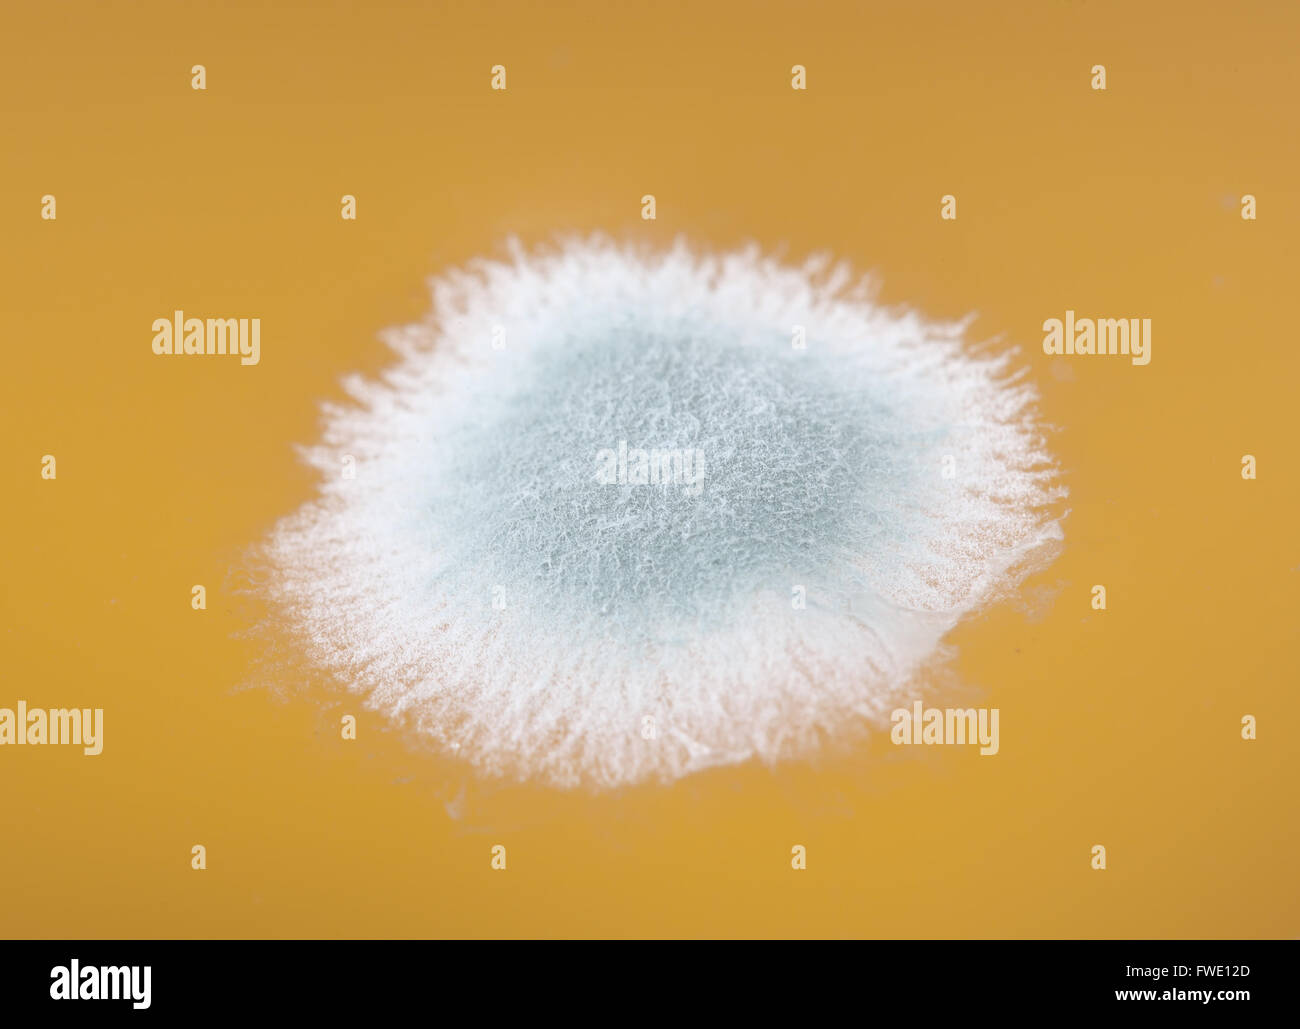
Schimmel im Orangensaft Makro Bild Stockfoto

Schnellfilter:
Spores reproduction Stockfotos & Bilder
 Schleimschimmelpilze, einst als Pilze klassifiziert, gehören jetzt zum Königreich der Protista. Diese Organismen vermehren sich mit Sporen und haben unterschiedliche Formen und Lebenszyklen. Stockfotohttps://www.alamy.de/image-license-details/?v=1https://www.alamy.de/stockfoto-schleimschimmelpilze-einst-als-pilze-klassifiziert-gehoren-jetzt-zum-konigreich-der-protista-diese-organismen-vermehren-sich-mit-sporen-und-haben-unterschiedliche-formen-und-lebenszyklen-129642701.html
Schleimschimmelpilze, einst als Pilze klassifiziert, gehören jetzt zum Königreich der Protista. Diese Organismen vermehren sich mit Sporen und haben unterschiedliche Formen und Lebenszyklen. Stockfotohttps://www.alamy.de/image-license-details/?v=1https://www.alamy.de/stockfoto-schleimschimmelpilze-einst-als-pilze-klassifiziert-gehoren-jetzt-zum-konigreich-der-protista-diese-organismen-vermehren-sich-mit-sporen-und-haben-unterschiedliche-formen-und-lebenszyklen-129642701.htmlRMHEWMGD–Schleimschimmelpilze, einst als Pilze klassifiziert, gehören jetzt zum Königreich der Protista. Diese Organismen vermehren sich mit Sporen und haben unterschiedliche Formen und Lebenszyklen.
 Schachtelhalme. Dieses Objekt ist Teil der Sammlung Bildung und Öffentlichkeitsarbeit, von denen einige im Q?rius Science Education Center sind und zu sehen sind.Paläozoikum - Permian114 Jan 2020 Stockfotohttps://www.alamy.de/image-license-details/?v=1https://www.alamy.de/schachtelhalme-dieses-objekt-ist-teil-der-sammlung-bildung-und-offentlichkeitsarbeit-von-denen-einige-im-qrius-science-education-center-sind-und-zu-sehen-sindpalaozoikum-permian114-jan-2020-image353463276.html
Schachtelhalme. Dieses Objekt ist Teil der Sammlung Bildung und Öffentlichkeitsarbeit, von denen einige im Q?rius Science Education Center sind und zu sehen sind.Paläozoikum - Permian114 Jan 2020 Stockfotohttps://www.alamy.de/image-license-details/?v=1https://www.alamy.de/schachtelhalme-dieses-objekt-ist-teil-der-sammlung-bildung-und-offentlichkeitsarbeit-von-denen-einige-im-qrius-science-education-center-sind-und-zu-sehen-sindpalaozoikum-permian114-jan-2020-image353463276.htmlRM2BF1J0C–Schachtelhalme. Dieses Objekt ist Teil der Sammlung Bildung und Öffentlichkeitsarbeit, von denen einige im Q?rius Science Education Center sind und zu sehen sind.Paläozoikum - Permian114 Jan 2020
 Dandelionkopf mit Sporen Stockfotohttps://www.alamy.de/image-license-details/?v=1https://www.alamy.de/dandelionkopf-mit-sporen-image612321989.html
Dandelionkopf mit Sporen Stockfotohttps://www.alamy.de/image-license-details/?v=1https://www.alamy.de/dandelionkopf-mit-sporen-image612321989.htmlRF2XG5JXD–Dandelionkopf mit Sporen
 Farn, Sporen, Selaginella Emmeliana zeigen Stockfotohttps://www.alamy.de/image-license-details/?v=1https://www.alamy.de/stockfoto-farn-sporen-selaginella-emmeliana-zeigen-73766445.html
Farn, Sporen, Selaginella Emmeliana zeigen Stockfotohttps://www.alamy.de/image-license-details/?v=1https://www.alamy.de/stockfoto-farn-sporen-selaginella-emmeliana-zeigen-73766445.htmlRME809RW–Farn, Sporen, Selaginella Emmeliana zeigen
 Coprinopsis picacea-Pilze. Seta de Coprinopsis picacea, Stockfotohttps://www.alamy.de/image-license-details/?v=1https://www.alamy.de/coprinopsis-picacea-pilze-seta-de-coprinopsis-picacea-image561086269.html
Coprinopsis picacea-Pilze. Seta de Coprinopsis picacea, Stockfotohttps://www.alamy.de/image-license-details/?v=1https://www.alamy.de/coprinopsis-picacea-pilze-seta-de-coprinopsis-picacea-image561086269.htmlRF2RGRK79–Coprinopsis picacea-Pilze. Seta de Coprinopsis picacea,
 Stand der großen Schachtelhalm (Equisteum Telmateia) Spore Kegel aus Kanalufer, Bathampton, Bad und nordöstlichen Somerset, UK, März. Stockfotohttps://www.alamy.de/image-license-details/?v=1https://www.alamy.de/stockfoto-stand-der-grossen-schachtelhalm-equisteum-telmateia-spore-kegel-aus-kanalufer-bathampton-bad-und-nordostlichen-somerset-uk-marz-139182881.html
Stand der großen Schachtelhalm (Equisteum Telmateia) Spore Kegel aus Kanalufer, Bathampton, Bad und nordöstlichen Somerset, UK, März. Stockfotohttps://www.alamy.de/image-license-details/?v=1https://www.alamy.de/stockfoto-stand-der-grossen-schachtelhalm-equisteum-telmateia-spore-kegel-aus-kanalufer-bathampton-bad-und-nordostlichen-somerset-uk-marz-139182881.htmlRMJ2C955–Stand der großen Schachtelhalm (Equisteum Telmateia) Spore Kegel aus Kanalufer, Bathampton, Bad und nordöstlichen Somerset, UK, März.
 Eine typische Darstellung einer Spore mit kreisförmigen Punkten, Vintage-Linienzeichnung oder Gravurillustration. Stock Vektorhttps://www.alamy.de/image-license-details/?v=1https://www.alamy.de/eine-typische-darstellung-einer-spore-mit-kreisformigen-punkten-vintage-linienzeichnung-oder-gravurillustration-image367210918.html
Eine typische Darstellung einer Spore mit kreisförmigen Punkten, Vintage-Linienzeichnung oder Gravurillustration. Stock Vektorhttps://www.alamy.de/image-license-details/?v=1https://www.alamy.de/eine-typische-darstellung-einer-spore-mit-kreisformigen-punkten-vintage-linienzeichnung-oder-gravurillustration-image367210918.htmlRF2C9BW7J–Eine typische Darstellung einer Spore mit kreisförmigen Punkten, Vintage-Linienzeichnung oder Gravurillustration.
 Spore Kapseln eines Mooses, Pohlia nutans Stockfotohttps://www.alamy.de/image-license-details/?v=1https://www.alamy.de/stockfoto-spore-kapseln-eines-mooses-pohlia-nutans-145996050.html
Spore Kapseln eines Mooses, Pohlia nutans Stockfotohttps://www.alamy.de/image-license-details/?v=1https://www.alamy.de/stockfoto-spore-kapseln-eines-mooses-pohlia-nutans-145996050.htmlRFJDEKCJ–Spore Kapseln eines Mooses, Pohlia nutans
 NAHAUFNAHME VON SORI AUF DER UNTERSEITE VON SCHWERT FERN WEDEL Stockfotohttps://www.alamy.de/image-license-details/?v=1https://www.alamy.de/nahaufnahme-von-sori-auf-der-unterseite-von-schwert-fern-wedel-image344625819.html
NAHAUFNAHME VON SORI AUF DER UNTERSEITE VON SCHWERT FERN WEDEL Stockfotohttps://www.alamy.de/image-license-details/?v=1https://www.alamy.de/nahaufnahme-von-sori-auf-der-unterseite-von-schwert-fern-wedel-image344625819.htmlRM2B0K1MY–NAHAUFNAHME VON SORI AUF DER UNTERSEITE VON SCHWERT FERN WEDEL
 Sporangium spore Struktur, die aus einem muskeltrainings Anlage Stockfotohttps://www.alamy.de/image-license-details/?v=1https://www.alamy.de/sporangium-spore-struktur-die-aus-einem-muskeltrainings-anlage-image233559085.html
Sporangium spore Struktur, die aus einem muskeltrainings Anlage Stockfotohttps://www.alamy.de/image-license-details/?v=1https://www.alamy.de/sporangium-spore-struktur-die-aus-einem-muskeltrainings-anlage-image233559085.htmlRFRFYEYW–Sporangium spore Struktur, die aus einem muskeltrainings Anlage
 Die detaillierte Untersuchung der Dryopteris filix-MAS-Blätter zeigt ihre komplizierte Textur und ihre reproduktiven Sporenpunkte, die die Schönheit dieser Ma unterstreichen Stockfotohttps://www.alamy.de/image-license-details/?v=1https://www.alamy.de/die-detaillierte-untersuchung-der-dryopteris-filix-mas-blatter-zeigt-ihre-komplizierte-textur-und-ihre-reproduktiven-sporenpunkte-die-die-schonheit-dieser-ma-unterstreichen-image698552029.html
Die detaillierte Untersuchung der Dryopteris filix-MAS-Blätter zeigt ihre komplizierte Textur und ihre reproduktiven Sporenpunkte, die die Schönheit dieser Ma unterstreichen Stockfotohttps://www.alamy.de/image-license-details/?v=1https://www.alamy.de/die-detaillierte-untersuchung-der-dryopteris-filix-mas-blatter-zeigt-ihre-komplizierte-textur-und-ihre-reproduktiven-sporenpunkte-die-die-schonheit-dieser-ma-unterstreichen-image698552029.htmlRF3CGDP6N–Die detaillierte Untersuchung der Dryopteris filix-MAS-Blätter zeigt ihre komplizierte Textur und ihre reproduktiven Sporenpunkte, die die Schönheit dieser Ma unterstreichen
 Der sich entwickelnde fertile Sporenstamm eines Horsetailfarns, Gattung Equisetum, im April. Das Genus Equisetum ist in der Pflanzenwelt einzigartig Stockfotohttps://www.alamy.de/image-license-details/?v=1https://www.alamy.de/der-sich-entwickelnde-fertile-sporenstamm-eines-horsetailfarns-gattung-equisetum-im-april-das-genus-equisetum-ist-in-der-pflanzenwelt-einzigartig-image352261944.html
Der sich entwickelnde fertile Sporenstamm eines Horsetailfarns, Gattung Equisetum, im April. Das Genus Equisetum ist in der Pflanzenwelt einzigartig Stockfotohttps://www.alamy.de/image-license-details/?v=1https://www.alamy.de/der-sich-entwickelnde-fertile-sporenstamm-eines-horsetailfarns-gattung-equisetum-im-april-das-genus-equisetum-ist-in-der-pflanzenwelt-einzigartig-image352261944.htmlRM2BD2WKM–Der sich entwickelnde fertile Sporenstamm eines Horsetailfarns, Gattung Equisetum, im April. Das Genus Equisetum ist in der Pflanzenwelt einzigartig
 Moos mit gelb-grünen Sporenkapseln, die auf einem Waldboden wachsen, in Makroaufnahmen mit weichem natürlichem Licht und geringer Schärfentiefe aufgenommen. Stockfotohttps://www.alamy.de/image-license-details/?v=1https://www.alamy.de/moos-mit-gelb-grunen-sporenkapseln-die-auf-einem-waldboden-wachsen-in-makroaufnahmen-mit-weichem-naturlichem-licht-und-geringer-scharfentiefe-aufgenommen-image691757578.html
Moos mit gelb-grünen Sporenkapseln, die auf einem Waldboden wachsen, in Makroaufnahmen mit weichem natürlichem Licht und geringer Schärfentiefe aufgenommen. Stockfotohttps://www.alamy.de/image-license-details/?v=1https://www.alamy.de/moos-mit-gelb-grunen-sporenkapseln-die-auf-einem-waldboden-wachsen-in-makroaufnahmen-mit-weichem-naturlichem-licht-und-geringer-scharfentiefe-aufgenommen-image691757578.htmlRF3C5C7RP–Moos mit gelb-grünen Sporenkapseln, die auf einem Waldboden wachsen, in Makroaufnahmen mit weichem natürlichem Licht und geringer Schärfentiefe aufgenommen.
 Sporenkoffer in dunkelbrauner oder schwarzer Linie an der Unterseite eines Farnblattes. Sie öffnen sich, um feine, Staub wie Sporen fallen, die den Farn zu reproduzieren Stockfotohttps://www.alamy.de/image-license-details/?v=1https://www.alamy.de/sporenkoffer-in-dunkelbrauner-oder-schwarzer-linie-an-der-unterseite-eines-farnblattes-sie-offnen-sich-um-feine-staub-wie-sporen-fallen-die-den-farn-zu-reproduzieren-image311789825.html
Sporenkoffer in dunkelbrauner oder schwarzer Linie an der Unterseite eines Farnblattes. Sie öffnen sich, um feine, Staub wie Sporen fallen, die den Farn zu reproduzieren Stockfotohttps://www.alamy.de/image-license-details/?v=1https://www.alamy.de/sporenkoffer-in-dunkelbrauner-oder-schwarzer-linie-an-der-unterseite-eines-farnblattes-sie-offnen-sich-um-feine-staub-wie-sporen-fallen-die-den-farn-zu-reproduzieren-image311789825.htmlRFS3772W–Sporenkoffer in dunkelbrauner oder schwarzer Linie an der Unterseite eines Farnblattes. Sie öffnen sich, um feine, Staub wie Sporen fallen, die den Farn zu reproduzieren
 Moos auf einer Trockenmauer auf Orrest Head oben Windermere im Lake District, Cumbria, England. Stockfotohttps://www.alamy.de/image-license-details/?v=1https://www.alamy.de/stockfoto-moos-auf-einer-trockenmauer-auf-orrest-head-oben-windermere-im-lake-district-cumbria-england-41842370.html
Moos auf einer Trockenmauer auf Orrest Head oben Windermere im Lake District, Cumbria, England. Stockfotohttps://www.alamy.de/image-license-details/?v=1https://www.alamy.de/stockfoto-moos-auf-einer-trockenmauer-auf-orrest-head-oben-windermere-im-lake-district-cumbria-england-41842370.htmlRMCC22AA–Moos auf einer Trockenmauer auf Orrest Head oben Windermere im Lake District, Cumbria, England.
 Marsh horsetail (Equisteum palustre) mit spore Kegel auf sumpfigen Boden um einen Teich, Cornwall, UK, April. Stockfotohttps://www.alamy.de/image-license-details/?v=1https://www.alamy.de/marsh-horsetail-equisteum-palustre-mit-spore-kegel-auf-sumpfigen-boden-um-einen-teich-cornwall-uk-april-image263061141.html
Marsh horsetail (Equisteum palustre) mit spore Kegel auf sumpfigen Boden um einen Teich, Cornwall, UK, April. Stockfotohttps://www.alamy.de/image-license-details/?v=1https://www.alamy.de/marsh-horsetail-equisteum-palustre-mit-spore-kegel-auf-sumpfigen-boden-um-einen-teich-cornwall-uk-april-image263061141.htmlRMW7YD4N–Marsh horsetail (Equisteum palustre) mit spore Kegel auf sumpfigen Boden um einen Teich, Cornwall, UK, April.
 Gewöhnliche Erdball-Skleroderma citrinum-Querschnitt, um die Sporenmasse der schwarzen Gleba zu zeigen Stockfotohttps://www.alamy.de/image-license-details/?v=1https://www.alamy.de/gewohnliche-erdball-skleroderma-citrinum-querschnitt-um-die-sporenmasse-der-schwarzen-gleba-zu-zeigen-image626884329.html
Gewöhnliche Erdball-Skleroderma citrinum-Querschnitt, um die Sporenmasse der schwarzen Gleba zu zeigen Stockfotohttps://www.alamy.de/image-license-details/?v=1https://www.alamy.de/gewohnliche-erdball-skleroderma-citrinum-querschnitt-um-die-sporenmasse-der-schwarzen-gleba-zu-zeigen-image626884329.htmlRM2YBW1A1–Gewöhnliche Erdball-Skleroderma citrinum-Querschnitt, um die Sporenmasse der schwarzen Gleba zu zeigen
 Epiphytisches Ribbon Ferns (Lepisorus sp. Vielleicht thunbergianus) mit sporentragenden Organen, Yungaburra, Atherton Tablelands, Queensland, Austtralia Stockfotohttps://www.alamy.de/image-license-details/?v=1https://www.alamy.de/epiphytisches-ribbon-ferns-lepisorus-sp-vielleicht-thunbergianus-mit-sporentragenden-organen-yungaburra-atherton-tablelands-queensland-austtralia-image698025459.html
Epiphytisches Ribbon Ferns (Lepisorus sp. Vielleicht thunbergianus) mit sporentragenden Organen, Yungaburra, Atherton Tablelands, Queensland, Austtralia Stockfotohttps://www.alamy.de/image-license-details/?v=1https://www.alamy.de/epiphytisches-ribbon-ferns-lepisorus-sp-vielleicht-thunbergianus-mit-sporentragenden-organen-yungaburra-atherton-tablelands-queensland-austtralia-image698025459.htmlRM3CFHPGK–Epiphytisches Ribbon Ferns (Lepisorus sp. Vielleicht thunbergianus) mit sporentragenden Organen, Yungaburra, Atherton Tablelands, Queensland, Austtralia
 Sporen auf der Unterseite eines Blattes Farn Stockfotohttps://www.alamy.de/image-license-details/?v=1https://www.alamy.de/stockfoto-sporen-auf-der-unterseite-eines-blattes-farn-58240748.html
Sporen auf der Unterseite eines Blattes Farn Stockfotohttps://www.alamy.de/image-license-details/?v=1https://www.alamy.de/stockfoto-sporen-auf-der-unterseite-eines-blattes-farn-58240748.htmlRFDAN2JM–Sporen auf der Unterseite eines Blattes Farn
 Eine Nahaufnahme des Korbpilzes, ein Mitglied der Stinkhornfamilie, veranschaulicht den einzigartigen Fortpflanzungsprozess. Der Pilz beginnt als eiartige Struktur und platzt schließlich auf, um übel riechende Sporen freizusetzen, die Fliegen für die Bestäubung anziehen. Stockfotohttps://www.alamy.de/image-license-details/?v=1https://www.alamy.de/stockfoto-eine-nahaufnahme-des-korbpilzes-ein-mitglied-der-stinkhornfamilie-veranschaulicht-den-einzigartigen-fortpflanzungsprozess-der-pilz-beginnt-als-eiartige-struktur-und-platzt-schliesslich-auf-um-ubel-riechende-sporen-freizusetzen-die-fliegen-fur-die-bestaubung-anziehen-129656405.html
Eine Nahaufnahme des Korbpilzes, ein Mitglied der Stinkhornfamilie, veranschaulicht den einzigartigen Fortpflanzungsprozess. Der Pilz beginnt als eiartige Struktur und platzt schließlich auf, um übel riechende Sporen freizusetzen, die Fliegen für die Bestäubung anziehen. Stockfotohttps://www.alamy.de/image-license-details/?v=1https://www.alamy.de/stockfoto-eine-nahaufnahme-des-korbpilzes-ein-mitglied-der-stinkhornfamilie-veranschaulicht-den-einzigartigen-fortpflanzungsprozess-der-pilz-beginnt-als-eiartige-struktur-und-platzt-schliesslich-auf-um-ubel-riechende-sporen-freizusetzen-die-fliegen-fur-die-bestaubung-anziehen-129656405.htmlRMHEXA1W–Eine Nahaufnahme des Korbpilzes, ein Mitglied der Stinkhornfamilie, veranschaulicht den einzigartigen Fortpflanzungsprozess. Der Pilz beginnt als eiartige Struktur und platzt schließlich auf, um übel riechende Sporen freizusetzen, die Fliegen für die Bestäubung anziehen.
 Horsetail. EO 401359 Horsetail Equisetum 001.jpg Stockfotohttps://www.alamy.de/image-license-details/?v=1https://www.alamy.de/horsetail-eo-401359-horsetail-equisetum-001jpg-image352147192.html
Horsetail. EO 401359 Horsetail Equisetum 001.jpg Stockfotohttps://www.alamy.de/image-license-details/?v=1https://www.alamy.de/horsetail-eo-401359-horsetail-equisetum-001jpg-image352147192.htmlRM2BCWK9C–Horsetail. EO 401359 Horsetail Equisetum 001.jpg
 Dandelionkopf mit Sporen Stockfotohttps://www.alamy.de/image-license-details/?v=1https://www.alamy.de/dandelionkopf-mit-sporen-image612321969.html
Dandelionkopf mit Sporen Stockfotohttps://www.alamy.de/image-license-details/?v=1https://www.alamy.de/dandelionkopf-mit-sporen-image612321969.htmlRF2XG5JWN–Dandelionkopf mit Sporen
 Aromenpalette Körper eines Pilzes auf feuchten Holzbrett Stockfotohttps://www.alamy.de/image-license-details/?v=1https://www.alamy.de/stockfoto-aromenpalette-korper-eines-pilzes-auf-feuchten-holzbrett-27215073.html
Aromenpalette Körper eines Pilzes auf feuchten Holzbrett Stockfotohttps://www.alamy.de/image-license-details/?v=1https://www.alamy.de/stockfoto-aromenpalette-korper-eines-pilzes-auf-feuchten-holzbrett-27215073.htmlRMBG7N2W–Aromenpalette Körper eines Pilzes auf feuchten Holzbrett
 Coprinopsis picacea-Pilze. Seta de Coprinopsis picacea, Stockfotohttps://www.alamy.de/image-license-details/?v=1https://www.alamy.de/coprinopsis-picacea-pilze-seta-de-coprinopsis-picacea-image561086268.html
Coprinopsis picacea-Pilze. Seta de Coprinopsis picacea, Stockfotohttps://www.alamy.de/image-license-details/?v=1https://www.alamy.de/coprinopsis-picacea-pilze-seta-de-coprinopsis-picacea-image561086268.htmlRF2RGRK78–Coprinopsis picacea-Pilze. Seta de Coprinopsis picacea,
 Dichten Stand der großen Schachtelhalm (Equisteum Telmateia) Spore Kegel aus Kanalufer, Bathampton, Bad und nordöstlichen Somerset, UK, März. Stockfotohttps://www.alamy.de/image-license-details/?v=1https://www.alamy.de/stockfoto-dichten-stand-der-grossen-schachtelhalm-equisteum-telmateia-spore-kegel-aus-kanalufer-bathampton-bad-und-nordostlichen-somerset-uk-marz-139182891.html
Dichten Stand der großen Schachtelhalm (Equisteum Telmateia) Spore Kegel aus Kanalufer, Bathampton, Bad und nordöstlichen Somerset, UK, März. Stockfotohttps://www.alamy.de/image-license-details/?v=1https://www.alamy.de/stockfoto-dichten-stand-der-grossen-schachtelhalm-equisteum-telmateia-spore-kegel-aus-kanalufer-bathampton-bad-und-nordostlichen-somerset-uk-marz-139182891.htmlRMJ2C95F–Dichten Stand der großen Schachtelhalm (Equisteum Telmateia) Spore Kegel aus Kanalufer, Bathampton, Bad und nordöstlichen Somerset, UK, März.
 Ein Bild, zwei sekundäre Sporen mit einander, vintage Strichzeichnung oder Gravur Abbildung verbunden. Stock Vektorhttps://www.alamy.de/image-license-details/?v=1https://www.alamy.de/ein-bild-zwei-sekundare-sporen-mit-einander-vintage-strichzeichnung-oder-gravur-abbildung-verbunden-image244666931.html
Ein Bild, zwei sekundäre Sporen mit einander, vintage Strichzeichnung oder Gravur Abbildung verbunden. Stock Vektorhttps://www.alamy.de/image-license-details/?v=1https://www.alamy.de/ein-bild-zwei-sekundare-sporen-mit-einander-vintage-strichzeichnung-oder-gravur-abbildung-verbunden-image244666931.htmlRFT61F4K–Ein Bild, zwei sekundäre Sporen mit einander, vintage Strichzeichnung oder Gravur Abbildung verbunden.
 Spore Kapseln eines grünen Mooses, Pohlia nutans Stockfotohttps://www.alamy.de/image-license-details/?v=1https://www.alamy.de/stockfoto-spore-kapseln-eines-grunen-mooses-pohlia-nutans-145996045.html
Spore Kapseln eines grünen Mooses, Pohlia nutans Stockfotohttps://www.alamy.de/image-license-details/?v=1https://www.alamy.de/stockfoto-spore-kapseln-eines-grunen-mooses-pohlia-nutans-145996045.htmlRFJDEKCD–Spore Kapseln eines grünen Mooses, Pohlia nutans
 Schneebesen Farn (Psilotum Nudum), Sprossen mit Spore Fällen Stockfotohttps://www.alamy.de/image-license-details/?v=1https://www.alamy.de/stockfoto-schneebesen-farn-psilotum-nudum-sprossen-mit-spore-fallen-76068002.html
Schneebesen Farn (Psilotum Nudum), Sprossen mit Spore Fällen Stockfotohttps://www.alamy.de/image-license-details/?v=1https://www.alamy.de/stockfoto-schneebesen-farn-psilotum-nudum-sprossen-mit-spore-fallen-76068002.htmlRMEBN5EA–Schneebesen Farn (Psilotum Nudum), Sprossen mit Spore Fällen
 Lebermoos-Spore-Kapsel. Leichte Schliffbild (LM). Längsschnitt durch die Thallus und Sporangien von einem Lebermoos (Pellia Epiphylla). Die Sporangien (Spore Kapseln, oben Mitte) ist innerhalb der Thallus-Fall (Calyptra) eingeschlossen. Die Sporangien ist dicht gepackt mit kugelförmigen Sporen (grün), die entfernt von Luftströmungen getragen werden, wenn die Sporangien offen geteilt wird. Vergrößerung: X20 wenn bei 10 cm breite gedruckt. Stockfotohttps://www.alamy.de/image-license-details/?v=1https://www.alamy.de/stockfoto-lebermoos-spore-kapsel-leichte-schliffbild-lm-langsschnitt-durch-die-thallus-und-sporangien-von-einem-lebermoos-pellia-epiphylla-die-sporangien-spore-kapseln-oben-mitte-ist-innerhalb-der-thallus-fall-calyptra-eingeschlossen-die-sporangien-ist-dicht-gepackt-mit-kugelformigen-sporen-grun-die-entfernt-von-luftstromungen-getragen-werden-wenn-die-sporangien-offen-geteilt-wird-vergrosserung-x20-wenn-bei-10-cm-breite-gedruckt-122807675.html
Lebermoos-Spore-Kapsel. Leichte Schliffbild (LM). Längsschnitt durch die Thallus und Sporangien von einem Lebermoos (Pellia Epiphylla). Die Sporangien (Spore Kapseln, oben Mitte) ist innerhalb der Thallus-Fall (Calyptra) eingeschlossen. Die Sporangien ist dicht gepackt mit kugelförmigen Sporen (grün), die entfernt von Luftströmungen getragen werden, wenn die Sporangien offen geteilt wird. Vergrößerung: X20 wenn bei 10 cm breite gedruckt. Stockfotohttps://www.alamy.de/image-license-details/?v=1https://www.alamy.de/stockfoto-lebermoos-spore-kapsel-leichte-schliffbild-lm-langsschnitt-durch-die-thallus-und-sporangien-von-einem-lebermoos-pellia-epiphylla-die-sporangien-spore-kapseln-oben-mitte-ist-innerhalb-der-thallus-fall-calyptra-eingeschlossen-die-sporangien-ist-dicht-gepackt-mit-kugelformigen-sporen-grun-die-entfernt-von-luftstromungen-getragen-werden-wenn-die-sporangien-offen-geteilt-wird-vergrosserung-x20-wenn-bei-10-cm-breite-gedruckt-122807675.htmlRFH3PACB–Lebermoos-Spore-Kapsel. Leichte Schliffbild (LM). Längsschnitt durch die Thallus und Sporangien von einem Lebermoos (Pellia Epiphylla). Die Sporangien (Spore Kapseln, oben Mitte) ist innerhalb der Thallus-Fall (Calyptra) eingeschlossen. Die Sporangien ist dicht gepackt mit kugelförmigen Sporen (grün), die entfernt von Luftströmungen getragen werden, wenn die Sporangien offen geteilt wird. Vergrößerung: X20 wenn bei 10 cm breite gedruckt.
 Sporenhaltiges Blatt auf Straußenfarn Pflanze matteuccia struthiopteris Stockfotohttps://www.alamy.de/image-license-details/?v=1https://www.alamy.de/sporenhaltiges-blatt-auf-straussenfarn-pflanze-matteuccia-struthiopteris-image451698124.html
Sporenhaltiges Blatt auf Straußenfarn Pflanze matteuccia struthiopteris Stockfotohttps://www.alamy.de/image-license-details/?v=1https://www.alamy.de/sporenhaltiges-blatt-auf-straussenfarn-pflanze-matteuccia-struthiopteris-image451698124.htmlRF2H6THFT–Sporenhaltiges Blatt auf Straußenfarn Pflanze matteuccia struthiopteris
 Der fruchtbare Sporenschaft eines Horsetailfarns, Gattung Equisetum, im April. Die Gattung Equisetum ist in der Pflanzenwelt einzigartig, da sie usi reproduzieren Stockfotohttps://www.alamy.de/image-license-details/?v=1https://www.alamy.de/der-fruchtbare-sporenschaft-eines-horsetailfarns-gattung-equisetum-im-april-die-gattung-equisetum-ist-in-der-pflanzenwelt-einzigartig-da-sie-usi-reproduzieren-image352264566.html
Der fruchtbare Sporenschaft eines Horsetailfarns, Gattung Equisetum, im April. Die Gattung Equisetum ist in der Pflanzenwelt einzigartig, da sie usi reproduzieren Stockfotohttps://www.alamy.de/image-license-details/?v=1https://www.alamy.de/der-fruchtbare-sporenschaft-eines-horsetailfarns-gattung-equisetum-im-april-die-gattung-equisetum-ist-in-der-pflanzenwelt-einzigartig-da-sie-usi-reproduzieren-image352264566.htmlRM2BD311A–Der fruchtbare Sporenschaft eines Horsetailfarns, Gattung Equisetum, im April. Die Gattung Equisetum ist in der Pflanzenwelt einzigartig, da sie usi reproduzieren
 Liverwort Pellia epiphylla, Wales, Großbritannien. Stockfotohttps://www.alamy.de/image-license-details/?v=1https://www.alamy.de/stockfoto-liverwort-pellia-epiphylla-wales-grossbritannien-19255990.html
Liverwort Pellia epiphylla, Wales, Großbritannien. Stockfotohttps://www.alamy.de/image-license-details/?v=1https://www.alamy.de/stockfoto-liverwort-pellia-epiphylla-wales-grossbritannien-19255990.htmlRMB3955X–Liverwort Pellia epiphylla, Wales, Großbritannien.
 Pneumoderma Stockfotohttps://www.alamy.de/image-license-details/?v=1https://www.alamy.de/stockfoto-pneumoderma-163206910.html
Pneumoderma Stockfotohttps://www.alamy.de/image-license-details/?v=1https://www.alamy.de/stockfoto-pneumoderma-163206910.htmlRMKDEM26–Pneumoderma
 Moos auf einer Trockenmauer auf Orrest Head oben Windermere im Lake District, Cumbria, England. Stockfotohttps://www.alamy.de/image-license-details/?v=1https://www.alamy.de/stockfoto-moos-auf-einer-trockenmauer-auf-orrest-head-oben-windermere-im-lake-district-cumbria-england-41842327.html
Moos auf einer Trockenmauer auf Orrest Head oben Windermere im Lake District, Cumbria, England. Stockfotohttps://www.alamy.de/image-license-details/?v=1https://www.alamy.de/stockfoto-moos-auf-einer-trockenmauer-auf-orrest-head-oben-windermere-im-lake-district-cumbria-england-41842327.htmlRMCC228R–Moos auf einer Trockenmauer auf Orrest Head oben Windermere im Lake District, Cumbria, England.
 Ein Makrofoto der Sori, Clustern von Sporangia, auf der Unterseite einer Farnwedel. Diese werden bei der Farnvermehrung verwendet. Stockfotohttps://www.alamy.de/image-license-details/?v=1https://www.alamy.de/ein-makrofoto-der-sori-clustern-von-sporangia-auf-der-unterseite-einer-farnwedel-diese-werden-bei-der-farnvermehrung-verwendet-image370659916.html
Ein Makrofoto der Sori, Clustern von Sporangia, auf der Unterseite einer Farnwedel. Diese werden bei der Farnvermehrung verwendet. Stockfotohttps://www.alamy.de/image-license-details/?v=1https://www.alamy.de/ein-makrofoto-der-sori-clustern-von-sporangia-auf-der-unterseite-einer-farnwedel-diese-werden-bei-der-farnvermehrung-verwendet-image370659916.htmlRM2CF10E4–Ein Makrofoto der Sori, Clustern von Sporangia, auf der Unterseite einer Farnwedel. Diese werden bei der Farnvermehrung verwendet.
 Cyathus olla, der Feldvogelnest-Pilz, mit dunklen Peridiolen in einem schalenförmigen Körper. Eine saprobische Spezies mit Spritzwassersporenstreuung durch Regentropfen Stockfotohttps://www.alamy.de/image-license-details/?v=1https://www.alamy.de/cyathus-olla-der-feldvogelnest-pilz-mit-dunklen-peridiolen-in-einem-schalenformigen-korper-eine-saprobische-spezies-mit-spritzwassersporenstreuung-durch-regentropfen-image708507550.html
Cyathus olla, der Feldvogelnest-Pilz, mit dunklen Peridiolen in einem schalenförmigen Körper. Eine saprobische Spezies mit Spritzwassersporenstreuung durch Regentropfen Stockfotohttps://www.alamy.de/image-license-details/?v=1https://www.alamy.de/cyathus-olla-der-feldvogelnest-pilz-mit-dunklen-peridiolen-in-einem-schalenformigen-korper-eine-saprobische-spezies-mit-spritzwassersporenstreuung-durch-regentropfen-image708507550.htmlRM3D4K8H2–Cyathus olla, der Feldvogelnest-Pilz, mit dunklen Peridiolen in einem schalenförmigen Körper. Eine saprobische Spezies mit Spritzwassersporenstreuung durch Regentropfen
 Staghorn-Clubmoos Lycopodiella cernua (auch bekannt als Palhinhaea cernua) mit nickenden reproduktiven Sporen produzierenden Strobili, Queensland, Australien Stockfotohttps://www.alamy.de/image-license-details/?v=1https://www.alamy.de/staghorn-clubmoos-lycopodiella-cernua-auch-bekannt-als-palhinhaea-cernua-mit-nickenden-reproduktiven-sporen-produzierenden-strobili-queensland-australien-image695995248.html
Staghorn-Clubmoos Lycopodiella cernua (auch bekannt als Palhinhaea cernua) mit nickenden reproduktiven Sporen produzierenden Strobili, Queensland, Australien Stockfotohttps://www.alamy.de/image-license-details/?v=1https://www.alamy.de/staghorn-clubmoos-lycopodiella-cernua-auch-bekannt-als-palhinhaea-cernua-mit-nickenden-reproduktiven-sporen-produzierenden-strobili-queensland-australien-image695995248.htmlRF3CC9914–Staghorn-Clubmoos Lycopodiella cernua (auch bekannt als Palhinhaea cernua) mit nickenden reproduktiven Sporen produzierenden Strobili, Queensland, Australien
 Sporen auf der Unterseite eines Blattes Farn Stockfotohttps://www.alamy.de/image-license-details/?v=1https://www.alamy.de/stockfoto-sporen-auf-der-unterseite-eines-blattes-farn-58240595.html
Sporen auf der Unterseite eines Blattes Farn Stockfotohttps://www.alamy.de/image-license-details/?v=1https://www.alamy.de/stockfoto-sporen-auf-der-unterseite-eines-blattes-farn-58240595.htmlRFDAN2D7–Sporen auf der Unterseite eines Blattes Farn
 Thaxterogaster porphyreum, allgemein bekannt als Veilchenpilz, ist ein Trüffel-ähnlicher Pilz, der in der Laubstreu von Buchenwäldern vorkommt. Die violette Kappe enthält Sporen produzierendes Gewebe, das Sporen freisetzt, wenn es zerfällt oder wenn Tiere das Gewebe verzehren. Stockfotohttps://www.alamy.de/image-license-details/?v=1https://www.alamy.de/stockfoto-thaxterogaster-porphyreum-allgemein-bekannt-als-veilchenpilz-ist-ein-truffel-ahnlicher-pilz-der-in-der-laubstreu-von-buchenwaldern-vorkommt-die-violette-kappe-enthalt-sporen-produzierendes-gewebe-das-sporen-freisetzt-wenn-es-zerfallt-oder-wenn-tiere-das-gewebe-verzehren-129645578.html
Thaxterogaster porphyreum, allgemein bekannt als Veilchenpilz, ist ein Trüffel-ähnlicher Pilz, der in der Laubstreu von Buchenwäldern vorkommt. Die violette Kappe enthält Sporen produzierendes Gewebe, das Sporen freisetzt, wenn es zerfällt oder wenn Tiere das Gewebe verzehren. Stockfotohttps://www.alamy.de/image-license-details/?v=1https://www.alamy.de/stockfoto-thaxterogaster-porphyreum-allgemein-bekannt-als-veilchenpilz-ist-ein-truffel-ahnlicher-pilz-der-in-der-laubstreu-von-buchenwaldern-vorkommt-die-violette-kappe-enthalt-sporen-produzierendes-gewebe-das-sporen-freisetzt-wenn-es-zerfallt-oder-wenn-tiere-das-gewebe-verzehren-129645578.htmlRMHEWT76–Thaxterogaster porphyreum, allgemein bekannt als Veilchenpilz, ist ein Trüffel-ähnlicher Pilz, der in der Laubstreu von Buchenwäldern vorkommt. Die violette Kappe enthält Sporen produzierendes Gewebe, das Sporen freisetzt, wenn es zerfällt oder wenn Tiere das Gewebe verzehren.
 Bryum synoicocaespiticium MLL Hal Kindb in Macoun Bryum synoicocaespiticium MLL Hal Kindb in Macoun. Stockfotohttps://www.alamy.de/image-license-details/?v=1https://www.alamy.de/bryum-synoicocaespiticium-mll-hal-kindb-in-macoun-bryum-synoicocaespiticium-mll-hal-kindb-in-macoun-image360496944.html
Bryum synoicocaespiticium MLL Hal Kindb in Macoun Bryum synoicocaespiticium MLL Hal Kindb in Macoun. Stockfotohttps://www.alamy.de/image-license-details/?v=1https://www.alamy.de/bryum-synoicocaespiticium-mll-hal-kindb-in-macoun-bryum-synoicocaespiticium-mll-hal-kindb-in-macoun-image360496944.htmlRM2BXE1ET–Bryum synoicocaespiticium MLL Hal Kindb in Macoun Bryum synoicocaespiticium MLL Hal Kindb in Macoun.
 Dandelionkopf mit Sporen Stockfotohttps://www.alamy.de/image-license-details/?v=1https://www.alamy.de/dandelionkopf-mit-sporen-image612321955.html
Dandelionkopf mit Sporen Stockfotohttps://www.alamy.de/image-license-details/?v=1https://www.alamy.de/dandelionkopf-mit-sporen-image612321955.htmlRF2XG5JW7–Dandelionkopf mit Sporen
 Phlebodium Aureum. Gewächshaus bei der königliche Botanische Garten. Madrid. Spanien Stockfotohttps://www.alamy.de/image-license-details/?v=1https://www.alamy.de/stockfoto-phlebodium-aureum-gewachshaus-bei-der-konigliche-botanische-garten-madrid-spanien-47770077.html
Phlebodium Aureum. Gewächshaus bei der königliche Botanische Garten. Madrid. Spanien Stockfotohttps://www.alamy.de/image-license-details/?v=1https://www.alamy.de/stockfoto-phlebodium-aureum-gewachshaus-bei-der-konigliche-botanische-garten-madrid-spanien-47770077.htmlRMCNM365–Phlebodium Aureum. Gewächshaus bei der königliche Botanische Garten. Madrid. Spanien
 Coprinopsis picacea-Pilze. Seta de Coprinopsis picacea, Stockfotohttps://www.alamy.de/image-license-details/?v=1https://www.alamy.de/coprinopsis-picacea-pilze-seta-de-coprinopsis-picacea-image561086272.html
Coprinopsis picacea-Pilze. Seta de Coprinopsis picacea, Stockfotohttps://www.alamy.de/image-license-details/?v=1https://www.alamy.de/coprinopsis-picacea-pilze-seta-de-coprinopsis-picacea-image561086272.htmlRF2RGRK7C–Coprinopsis picacea-Pilze. Seta de Coprinopsis picacea,
 Dichten Stand der großen Schachtelhalm (Equisteum Telmateia) Spore Kegel aus Kanalufer, Bathampton, Bad und nordöstlichen Somerset, UK, März. Stockfotohttps://www.alamy.de/image-license-details/?v=1https://www.alamy.de/stockfoto-dichten-stand-der-grossen-schachtelhalm-equisteum-telmateia-spore-kegel-aus-kanalufer-bathampton-bad-und-nordostlichen-somerset-uk-marz-139182884.html
Dichten Stand der großen Schachtelhalm (Equisteum Telmateia) Spore Kegel aus Kanalufer, Bathampton, Bad und nordöstlichen Somerset, UK, März. Stockfotohttps://www.alamy.de/image-license-details/?v=1https://www.alamy.de/stockfoto-dichten-stand-der-grossen-schachtelhalm-equisteum-telmateia-spore-kegel-aus-kanalufer-bathampton-bad-und-nordostlichen-somerset-uk-marz-139182884.htmlRMJ2C958–Dichten Stand der großen Schachtelhalm (Equisteum Telmateia) Spore Kegel aus Kanalufer, Bathampton, Bad und nordöstlichen Somerset, UK, März.
 Spore Kapseln Stockfotohttps://www.alamy.de/image-license-details/?v=1https://www.alamy.de/stockfoto-spore-kapseln-103531672.html
Spore Kapseln Stockfotohttps://www.alamy.de/image-license-details/?v=1https://www.alamy.de/stockfoto-spore-kapseln-103531672.htmlRMG0C7KM–Spore Kapseln
 Spore Kapseln eines grünen Mooses, Pohlia nutans Stockfotohttps://www.alamy.de/image-license-details/?v=1https://www.alamy.de/stockfoto-spore-kapseln-eines-grunen-mooses-pohlia-nutans-145996047.html
Spore Kapseln eines grünen Mooses, Pohlia nutans Stockfotohttps://www.alamy.de/image-license-details/?v=1https://www.alamy.de/stockfoto-spore-kapseln-eines-grunen-mooses-pohlia-nutans-145996047.htmlRFJDEKCF–Spore Kapseln eines grünen Mooses, Pohlia nutans
 Europäische Strauß Farn, Strauß Farn (Matteuccia Struthiopteris), Spore Fällen, Deutschland Stockfotohttps://www.alamy.de/image-license-details/?v=1https://www.alamy.de/stockfoto-europaische-strauss-farn-strauss-farn-matteuccia-struthiopteris-spore-fallen-deutschland-76064319.html
Europäische Strauß Farn, Strauß Farn (Matteuccia Struthiopteris), Spore Fällen, Deutschland Stockfotohttps://www.alamy.de/image-license-details/?v=1https://www.alamy.de/stockfoto-europaische-strauss-farn-strauss-farn-matteuccia-struthiopteris-spore-fallen-deutschland-76064319.htmlRMEBN0PR–Europäische Strauß Farn, Strauß Farn (Matteuccia Struthiopteris), Spore Fällen, Deutschland
 Lebermoos-Spore-Kapsel. Leichte Schliffbild (LM). Längsschnitt durch die Thallus und Sporangien von einem Lebermoos (Pellia Epiphylla). Die Sporangien (Spore Kapseln, oben Mitte) ist innerhalb der Thallus-Fall (Calyptra) eingeschlossen. Die Sporangien ist dicht gepackt mit kugelförmigen Sporen (rot), die entfernt von Luftströmungen getragen werden, wenn die Sporangien offen geteilt wird. Vergrößerung: X20 wenn bei 10 cm breite gedruckt. Stockfotohttps://www.alamy.de/image-license-details/?v=1https://www.alamy.de/stockfoto-lebermoos-spore-kapsel-leichte-schliffbild-lm-langsschnitt-durch-die-thallus-und-sporangien-von-einem-lebermoos-pellia-epiphylla-die-sporangien-spore-kapseln-oben-mitte-ist-innerhalb-der-thallus-fall-calyptra-eingeschlossen-die-sporangien-ist-dicht-gepackt-mit-kugelformigen-sporen-rot-die-entfernt-von-luftstromungen-getragen-werden-wenn-die-sporangien-offen-geteilt-wird-vergrosserung-x20-wenn-bei-10-cm-breite-gedruckt-122807645.html
Lebermoos-Spore-Kapsel. Leichte Schliffbild (LM). Längsschnitt durch die Thallus und Sporangien von einem Lebermoos (Pellia Epiphylla). Die Sporangien (Spore Kapseln, oben Mitte) ist innerhalb der Thallus-Fall (Calyptra) eingeschlossen. Die Sporangien ist dicht gepackt mit kugelförmigen Sporen (rot), die entfernt von Luftströmungen getragen werden, wenn die Sporangien offen geteilt wird. Vergrößerung: X20 wenn bei 10 cm breite gedruckt. Stockfotohttps://www.alamy.de/image-license-details/?v=1https://www.alamy.de/stockfoto-lebermoos-spore-kapsel-leichte-schliffbild-lm-langsschnitt-durch-die-thallus-und-sporangien-von-einem-lebermoos-pellia-epiphylla-die-sporangien-spore-kapseln-oben-mitte-ist-innerhalb-der-thallus-fall-calyptra-eingeschlossen-die-sporangien-ist-dicht-gepackt-mit-kugelformigen-sporen-rot-die-entfernt-von-luftstromungen-getragen-werden-wenn-die-sporangien-offen-geteilt-wird-vergrosserung-x20-wenn-bei-10-cm-breite-gedruckt-122807645.htmlRFH3PAB9–Lebermoos-Spore-Kapsel. Leichte Schliffbild (LM). Längsschnitt durch die Thallus und Sporangien von einem Lebermoos (Pellia Epiphylla). Die Sporangien (Spore Kapseln, oben Mitte) ist innerhalb der Thallus-Fall (Calyptra) eingeschlossen. Die Sporangien ist dicht gepackt mit kugelförmigen Sporen (rot), die entfernt von Luftströmungen getragen werden, wenn die Sporangien offen geteilt wird. Vergrößerung: X20 wenn bei 10 cm breite gedruckt.
 Sporenhaltiges Blatt auf Straußenfarn Pflanze matteuccia struthiopteris Stockfotohttps://www.alamy.de/image-license-details/?v=1https://www.alamy.de/sporenhaltiges-blatt-auf-straussenfarn-pflanze-matteuccia-struthiopteris-image451698135.html
Sporenhaltiges Blatt auf Straußenfarn Pflanze matteuccia struthiopteris Stockfotohttps://www.alamy.de/image-license-details/?v=1https://www.alamy.de/sporenhaltiges-blatt-auf-straussenfarn-pflanze-matteuccia-struthiopteris-image451698135.htmlRF2H6THG7–Sporenhaltiges Blatt auf Straußenfarn Pflanze matteuccia struthiopteris
 Der fruchtbare Sporenschaft eines Horsetailfarns, Gattung Equisetum, im April. Die Gattung Equisetum ist in der Pflanzenwelt einzigartig, da sie usi reproduzieren Stockfotohttps://www.alamy.de/image-license-details/?v=1https://www.alamy.de/der-fruchtbare-sporenschaft-eines-horsetailfarns-gattung-equisetum-im-april-die-gattung-equisetum-ist-in-der-pflanzenwelt-einzigartig-da-sie-usi-reproduzieren-image352265011.html
Der fruchtbare Sporenschaft eines Horsetailfarns, Gattung Equisetum, im April. Die Gattung Equisetum ist in der Pflanzenwelt einzigartig, da sie usi reproduzieren Stockfotohttps://www.alamy.de/image-license-details/?v=1https://www.alamy.de/der-fruchtbare-sporenschaft-eines-horsetailfarns-gattung-equisetum-im-april-die-gattung-equisetum-ist-in-der-pflanzenwelt-einzigartig-da-sie-usi-reproduzieren-image352265011.htmlRM2BD31H7–Der fruchtbare Sporenschaft eines Horsetailfarns, Gattung Equisetum, im April. Die Gattung Equisetum ist in der Pflanzenwelt einzigartig, da sie usi reproduzieren
 Liverwort Pellia epiphylla, Wales, Großbritannien. Stockfotohttps://www.alamy.de/image-license-details/?v=1https://www.alamy.de/stockfoto-liverwort-pellia-epiphylla-wales-grossbritannien-18766685.html
Liverwort Pellia epiphylla, Wales, Großbritannien. Stockfotohttps://www.alamy.de/image-license-details/?v=1https://www.alamy.de/stockfoto-liverwort-pellia-epiphylla-wales-grossbritannien-18766685.htmlRMB2EW2N–Liverwort Pellia epiphylla, Wales, Großbritannien.
 Kleiner Pilz mit Spore um in die Luft fliegen. Stockfotohttps://www.alamy.de/image-license-details/?v=1https://www.alamy.de/stockfoto-kleiner-pilz-mit-spore-um-in-die-luft-fliegen-124316281.html
Kleiner Pilz mit Spore um in die Luft fliegen. Stockfotohttps://www.alamy.de/image-license-details/?v=1https://www.alamy.de/stockfoto-kleiner-pilz-mit-spore-um-in-die-luft-fliegen-124316281.htmlRFH672K5–Kleiner Pilz mit Spore um in die Luft fliegen.
 Sporen in der sporangien auf der Unterseite der Wedel von Dryopteris erythrosora, Hardy immergrüner Farn Stockfotohttps://www.alamy.de/image-license-details/?v=1https://www.alamy.de/sporen-in-der-sporangien-auf-der-unterseite-der-wedel-von-dryopteris-erythrosora-hardy-immergruner-farn-image159210959.html
Sporen in der sporangien auf der Unterseite der Wedel von Dryopteris erythrosora, Hardy immergrüner Farn Stockfotohttps://www.alamy.de/image-license-details/?v=1https://www.alamy.de/sporen-in-der-sporangien-auf-der-unterseite-der-wedel-von-dryopteris-erythrosora-hardy-immergruner-farn-image159210959.htmlRMK70K5K–Sporen in der sporangien auf der Unterseite der Wedel von Dryopteris erythrosora, Hardy immergrüner Farn
 Ein kleineren Farn mit Sporen auf seiner Unterseite vor einem gefällten Erle Baum in einem Wald in der Nähe von Dulverton, Devon, UK. Stockfotohttps://www.alamy.de/image-license-details/?v=1https://www.alamy.de/stockfoto-ein-kleineren-farn-mit-sporen-auf-seiner-unterseite-vor-einem-gefallten-erle-baum-in-einem-wald-in-der-nahe-von-dulverton-devon-uk-39347911.html
Ein kleineren Farn mit Sporen auf seiner Unterseite vor einem gefällten Erle Baum in einem Wald in der Nähe von Dulverton, Devon, UK. Stockfotohttps://www.alamy.de/image-license-details/?v=1https://www.alamy.de/stockfoto-ein-kleineren-farn-mit-sporen-auf-seiner-unterseite-vor-einem-gefallten-erle-baum-in-einem-wald-in-der-nahe-von-dulverton-devon-uk-39347911.htmlRMC80CJF–Ein kleineren Farn mit Sporen auf seiner Unterseite vor einem gefällten Erle Baum in einem Wald in der Nähe von Dulverton, Devon, UK.
 Cyathus olla, der Feldvogelnest-Pilz, mit dunklen Peridiolen in einem schalenförmigen Körper. Eine saprobische Spezies mit Spritzwassersporenstreuung durch Regentropfen Stockfotohttps://www.alamy.de/image-license-details/?v=1https://www.alamy.de/cyathus-olla-der-feldvogelnest-pilz-mit-dunklen-peridiolen-in-einem-schalenformigen-korper-eine-saprobische-spezies-mit-spritzwassersporenstreuung-durch-regentropfen-image708507552.html
Cyathus olla, der Feldvogelnest-Pilz, mit dunklen Peridiolen in einem schalenförmigen Körper. Eine saprobische Spezies mit Spritzwassersporenstreuung durch Regentropfen Stockfotohttps://www.alamy.de/image-license-details/?v=1https://www.alamy.de/cyathus-olla-der-feldvogelnest-pilz-mit-dunklen-peridiolen-in-einem-schalenformigen-korper-eine-saprobische-spezies-mit-spritzwassersporenstreuung-durch-regentropfen-image708507552.htmlRM3D4K8H4–Cyathus olla, der Feldvogelnest-Pilz, mit dunklen Peridiolen in einem schalenförmigen Körper. Eine saprobische Spezies mit Spritzwassersporenstreuung durch Regentropfen
 In der Luft Pollenkörner, Heuschnupfen, Pollenallergie Stockfotohttps://www.alamy.de/image-license-details/?v=1https://www.alamy.de/stockfoto-in-der-luft-pollenkorner-heuschnupfen-pollenallergie-120637838.html
In der Luft Pollenkörner, Heuschnupfen, Pollenallergie Stockfotohttps://www.alamy.de/image-license-details/?v=1https://www.alamy.de/stockfoto-in-der-luft-pollenkorner-heuschnupfen-pollenallergie-120637838.htmlRFH07EP6–In der Luft Pollenkörner, Heuschnupfen, Pollenallergie
 Sporen auf der Unterseite eines Blattes Farn Stockfotohttps://www.alamy.de/image-license-details/?v=1https://www.alamy.de/stockfoto-sporen-auf-der-unterseite-eines-blattes-farn-58241268.html
Sporen auf der Unterseite eines Blattes Farn Stockfotohttps://www.alamy.de/image-license-details/?v=1https://www.alamy.de/stockfoto-sporen-auf-der-unterseite-eines-blattes-farn-58241268.htmlRFDAN398–Sporen auf der Unterseite eines Blattes Farn
 Schleimschimmelpilze sind einzigartige Organismen, die Sporen zur Fortpflanzung verwenden. Früher als Pilze klassifiziert, gelten sie heute als Teil des Königreichs Protista. Diese Organismen kommen in einer Vielzahl von Farben und Formen vor, mit über 900 Arten weltweit. Stockfotohttps://www.alamy.de/image-license-details/?v=1https://www.alamy.de/stockfoto-schleimschimmelpilze-sind-einzigartige-organismen-die-sporen-zur-fortpflanzung-verwenden-fruher-als-pilze-klassifiziert-gelten-sie-heute-als-teil-des-konigreichs-protista-diese-organismen-kommen-in-einer-vielzahl-von-farben-und-formen-vor-mit-uber-900-arten-weltweit-129656099.html
Schleimschimmelpilze sind einzigartige Organismen, die Sporen zur Fortpflanzung verwenden. Früher als Pilze klassifiziert, gelten sie heute als Teil des Königreichs Protista. Diese Organismen kommen in einer Vielzahl von Farben und Formen vor, mit über 900 Arten weltweit. Stockfotohttps://www.alamy.de/image-license-details/?v=1https://www.alamy.de/stockfoto-schleimschimmelpilze-sind-einzigartige-organismen-die-sporen-zur-fortpflanzung-verwenden-fruher-als-pilze-klassifiziert-gelten-sie-heute-als-teil-des-konigreichs-protista-diese-organismen-kommen-in-einer-vielzahl-von-farben-und-formen-vor-mit-uber-900-arten-weltweit-129656099.htmlRMHEX9JY–Schleimschimmelpilze sind einzigartige Organismen, die Sporen zur Fortpflanzung verwenden. Früher als Pilze klassifiziert, gelten sie heute als Teil des Königreichs Protista. Diese Organismen kommen in einer Vielzahl von Farben und Formen vor, mit über 900 Arten weltweit.
 Blühende Pflanzen und Farne Blühende Pflanzen und Farne. Stockfotohttps://www.alamy.de/image-license-details/?v=1https://www.alamy.de/bluhende-pflanzen-und-farne-bluhende-pflanzen-und-farne-image362266999.html
Blühende Pflanzen und Farne Blühende Pflanzen und Farne. Stockfotohttps://www.alamy.de/image-license-details/?v=1https://www.alamy.de/bluhende-pflanzen-und-farne-bluhende-pflanzen-und-farne-image362266999.htmlRM2C1AK73–Blühende Pflanzen und Farne Blühende Pflanzen und Farne.
 Sporen, englisches Reiten Stockfotohttps://www.alamy.de/image-license-details/?v=1https://www.alamy.de/sporen-englisches-reiten-image553979633.html
Sporen, englisches Reiten Stockfotohttps://www.alamy.de/image-license-details/?v=1https://www.alamy.de/sporen-englisches-reiten-image553979633.htmlRM2R57XJW–Sporen, englisches Reiten
 Bryum capillare im amazonaswald Stockfotohttps://www.alamy.de/image-license-details/?v=1https://www.alamy.de/bryum-capillare-im-amazonaswald-image621851554.html
Bryum capillare im amazonaswald Stockfotohttps://www.alamy.de/image-license-details/?v=1https://www.alamy.de/bryum-capillare-im-amazonaswald-image621851554.htmlRM2Y3KP02–Bryum capillare im amazonaswald
 Pilze im Wald. Setas en el bosque. Stockfotohttps://www.alamy.de/image-license-details/?v=1https://www.alamy.de/pilze-im-wald-setas-en-el-bosque-image560811316.html
Pilze im Wald. Setas en el bosque. Stockfotohttps://www.alamy.de/image-license-details/?v=1https://www.alamy.de/pilze-im-wald-setas-en-el-bosque-image560811316.htmlRF2RGB4FG–Pilze im Wald. Setas en el bosque.
 Marsh Schachtelhalm (Equisteum palustre) Sporenzapfen, Kenfig NNR, Glamorgan, Wales, Vereinigtes Königreich, Mai. Stockfotohttps://www.alamy.de/image-license-details/?v=1https://www.alamy.de/marsh-schachtelhalm-equisteum-palustre-sporenzapfen-kenfig-nnr-glamorgan-wales-vereinigtes-konigreich-mai-image478425112.html
Marsh Schachtelhalm (Equisteum palustre) Sporenzapfen, Kenfig NNR, Glamorgan, Wales, Vereinigtes Königreich, Mai. Stockfotohttps://www.alamy.de/image-license-details/?v=1https://www.alamy.de/marsh-schachtelhalm-equisteum-palustre-sporenzapfen-kenfig-nnr-glamorgan-wales-vereinigtes-konigreich-mai-image478425112.htmlRM2JPA434–Marsh Schachtelhalm (Equisteum palustre) Sporenzapfen, Kenfig NNR, Glamorgan, Wales, Vereinigtes Königreich, Mai.
 . Français: Planche d'Abbildung de l'Atlas de Botanique d'Arnold Dodel-Port de l'Espèce (marchantia Archegonium & Antheridium). 17 April 2014, 08:23:30 Uhr. Carolina et Arnold Dodel-Port 142 Dodel-Port Atlas (marchantia Archegonium &Amp; Antheridium) XVII. Stockfotohttps://www.alamy.de/image-license-details/?v=1https://www.alamy.de/franais-planche-dabbildung-de-latlas-de-botanique-darnold-dodel-port-de-lespce-marchantia-archegonium-antheridium-17-april-2014-082330-uhr-carolina-et-arnold-dodel-port-142-dodel-port-atlas-marchantia-archegonium-amp-antheridium-xvii-image188852914.html
. Français: Planche d'Abbildung de l'Atlas de Botanique d'Arnold Dodel-Port de l'Espèce (marchantia Archegonium & Antheridium). 17 April 2014, 08:23:30 Uhr. Carolina et Arnold Dodel-Port 142 Dodel-Port Atlas (marchantia Archegonium &Amp; Antheridium) XVII. Stockfotohttps://www.alamy.de/image-license-details/?v=1https://www.alamy.de/franais-planche-dabbildung-de-latlas-de-botanique-darnold-dodel-port-de-lespce-marchantia-archegonium-antheridium-17-april-2014-082330-uhr-carolina-et-arnold-dodel-port-142-dodel-port-atlas-marchantia-archegonium-amp-antheridium-xvii-image188852914.htmlRMMY6YPX–. Français: Planche d'Abbildung de l'Atlas de Botanique d'Arnold Dodel-Port de l'Espèce (marchantia Archegonium & Antheridium). 17 April 2014, 08:23:30 Uhr. Carolina et Arnold Dodel-Port 142 Dodel-Port Atlas (marchantia Archegonium &Amp; Antheridium) XVII.
 Spore Kapseln eines Mooses, Pohlia nutans Stockfotohttps://www.alamy.de/image-license-details/?v=1https://www.alamy.de/spore-kapseln-eines-mooses-pohlia-nutans-image185133369.html
Spore Kapseln eines Mooses, Pohlia nutans Stockfotohttps://www.alamy.de/image-license-details/?v=1https://www.alamy.de/spore-kapseln-eines-mooses-pohlia-nutans-image185133369.htmlRFMN5FE1–Spore Kapseln eines Mooses, Pohlia nutans
 Großer Horsetail (Equisetum telmateia, Equisetum telmateja, Equisetum Maximum), sporetragender Strobilus, Deutschland, Bayern Stockfotohttps://www.alamy.de/image-license-details/?v=1https://www.alamy.de/grosser-horsetail-equisetum-telmateia-equisetum-telmateja-equisetum-maximum-sporetragender-strobilus-deutschland-bayern-image345027710.html
Großer Horsetail (Equisetum telmateia, Equisetum telmateja, Equisetum Maximum), sporetragender Strobilus, Deutschland, Bayern Stockfotohttps://www.alamy.de/image-license-details/?v=1https://www.alamy.de/grosser-horsetail-equisetum-telmateia-equisetum-telmateja-equisetum-maximum-sporetragender-strobilus-deutschland-bayern-image345027710.htmlRM2B19AA6–Großer Horsetail (Equisetum telmateia, Equisetum telmateja, Equisetum Maximum), sporetragender Strobilus, Deutschland, Bayern
 Pilzartige Fruchtkörper, Abbildung Stockfotohttps://www.alamy.de/image-license-details/?v=1https://www.alamy.de/pilzartige-fruchtkorper-abbildung-image332250575.html
Pilzartige Fruchtkörper, Abbildung Stockfotohttps://www.alamy.de/image-license-details/?v=1https://www.alamy.de/pilzartige-fruchtkorper-abbildung-image332250575.htmlRF2A8F8YY–Pilzartige Fruchtkörper, Abbildung
 Sporenhaltiges Blatt auf Straußenfarn Pflanze matteuccia struthiopteris Stockfotohttps://www.alamy.de/image-license-details/?v=1https://www.alamy.de/sporenhaltiges-blatt-auf-straussenfarn-pflanze-matteuccia-struthiopteris-image451698120.html
Sporenhaltiges Blatt auf Straußenfarn Pflanze matteuccia struthiopteris Stockfotohttps://www.alamy.de/image-license-details/?v=1https://www.alamy.de/sporenhaltiges-blatt-auf-straussenfarn-pflanze-matteuccia-struthiopteris-image451698120.htmlRF2H6THFM–Sporenhaltiges Blatt auf Straußenfarn Pflanze matteuccia struthiopteris
 Die fruchtbaren, sporentragenden Stängel von Horseetail-Farnen, Gattung Equisetum, die im April seitlich einer Straße wachsen. Die Gattung Equisetum ist einzigartig in der Pla Stockfotohttps://www.alamy.de/image-license-details/?v=1https://www.alamy.de/die-fruchtbaren-sporentragenden-stangel-von-horseetail-farnen-gattung-equisetum-die-im-april-seitlich-einer-strasse-wachsen-die-gattung-equisetum-ist-einzigartig-in-der-pla-image352263546.html
Die fruchtbaren, sporentragenden Stängel von Horseetail-Farnen, Gattung Equisetum, die im April seitlich einer Straße wachsen. Die Gattung Equisetum ist einzigartig in der Pla Stockfotohttps://www.alamy.de/image-license-details/?v=1https://www.alamy.de/die-fruchtbaren-sporentragenden-stangel-von-horseetail-farnen-gattung-equisetum-die-im-april-seitlich-einer-strasse-wachsen-die-gattung-equisetum-ist-einzigartig-in-der-pla-image352263546.htmlRM2BD2YMX–Die fruchtbaren, sporentragenden Stängel von Horseetail-Farnen, Gattung Equisetum, die im April seitlich einer Straße wachsen. Die Gattung Equisetum ist einzigartig in der Pla
 Sporen auf der Unterseite eines Farns, Wales, Großbritannien. Stockfotohttps://www.alamy.de/image-license-details/?v=1https://www.alamy.de/stockfoto-sporen-auf-der-unterseite-eines-farns-wales-grossbritannien-14453663.html
Sporen auf der Unterseite eines Farns, Wales, Großbritannien. Stockfotohttps://www.alamy.de/image-license-details/?v=1https://www.alamy.de/stockfoto-sporen-auf-der-unterseite-eines-farns-wales-grossbritannien-14453663.htmlRMAHEYET–Sporen auf der Unterseite eines Farns, Wales, Großbritannien.
 Sporangie auf Farn. Sporanges-Gruppen auf Farnblättern. Reproduktion von Polypodiopsida oder Polypodiophyta. Schönheit in der Natur. Stockfotohttps://www.alamy.de/image-license-details/?v=1https://www.alamy.de/sporangie-auf-farn-sporanges-gruppen-auf-farnblattern-reproduktion-von-polypodiopsida-oder-polypodiophyta-schonheit-in-der-natur-image467020168.html
Sporangie auf Farn. Sporanges-Gruppen auf Farnblättern. Reproduktion von Polypodiopsida oder Polypodiophyta. Schönheit in der Natur. Stockfotohttps://www.alamy.de/image-license-details/?v=1https://www.alamy.de/sporangie-auf-farn-sporanges-gruppen-auf-farnblattern-reproduktion-von-polypodiopsida-oder-polypodiophyta-schonheit-in-der-natur-image467020168.htmlRF2J3PGYM–Sporangie auf Farn. Sporanges-Gruppen auf Farnblättern. Reproduktion von Polypodiopsida oder Polypodiophyta. Schönheit in der Natur.
 Sporen in der sporangien auf der Unterseite der Wedel von Dryopteris erythrosora, Hardy immergrüner Farn Stockfotohttps://www.alamy.de/image-license-details/?v=1https://www.alamy.de/sporen-in-der-sporangien-auf-der-unterseite-der-wedel-von-dryopteris-erythrosora-hardy-immergruner-farn-image159210957.html
Sporen in der sporangien auf der Unterseite der Wedel von Dryopteris erythrosora, Hardy immergrüner Farn Stockfotohttps://www.alamy.de/image-license-details/?v=1https://www.alamy.de/sporen-in-der-sporangien-auf-der-unterseite-der-wedel-von-dryopteris-erythrosora-hardy-immergruner-farn-image159210957.htmlRMK70K5H–Sporen in der sporangien auf der Unterseite der Wedel von Dryopteris erythrosora, Hardy immergrüner Farn
 Der Acker-Schachtelhalm zeigt einen schlanken, unverzweigten Stiel, der im Frühling mit einem Sporenkegel gekrönt ist, der seine einzigartige Struktur gegen einen verschwommenen Grinsen hervorhebt Stockfotohttps://www.alamy.de/image-license-details/?v=1https://www.alamy.de/der-acker-schachtelhalm-zeigt-einen-schlanken-unverzweigten-stiel-der-im-fruhling-mit-einem-sporenkegel-gekront-ist-der-seine-einzigartige-struktur-gegen-einen-verschwommenen-grinsen-hervorhebt-image686279499.html
Der Acker-Schachtelhalm zeigt einen schlanken, unverzweigten Stiel, der im Frühling mit einem Sporenkegel gekrönt ist, der seine einzigartige Struktur gegen einen verschwommenen Grinsen hervorhebt Stockfotohttps://www.alamy.de/image-license-details/?v=1https://www.alamy.de/der-acker-schachtelhalm-zeigt-einen-schlanken-unverzweigten-stiel-der-im-fruhling-mit-einem-sporenkegel-gekront-ist-der-seine-einzigartige-struktur-gegen-einen-verschwommenen-grinsen-hervorhebt-image686279499.htmlRF3BTEME3–Der Acker-Schachtelhalm zeigt einen schlanken, unverzweigten Stiel, der im Frühling mit einem Sporenkegel gekrönt ist, der seine einzigartige Struktur gegen einen verschwommenen Grinsen hervorhebt
 Nahaufnahme von Moos mit Sporenkapseln in einem Wald, aufgenommen bei weichem Tageslicht mit geringer Schärfentiefe und natürlichen grünen Texturen. Stockfotohttps://www.alamy.de/image-license-details/?v=1https://www.alamy.de/nahaufnahme-von-moos-mit-sporenkapseln-in-einem-wald-aufgenommen-bei-weichem-tageslicht-mit-geringer-scharfentiefe-und-naturlichen-grunen-texturen-image691757577.html
Nahaufnahme von Moos mit Sporenkapseln in einem Wald, aufgenommen bei weichem Tageslicht mit geringer Schärfentiefe und natürlichen grünen Texturen. Stockfotohttps://www.alamy.de/image-license-details/?v=1https://www.alamy.de/nahaufnahme-von-moos-mit-sporenkapseln-in-einem-wald-aufgenommen-bei-weichem-tageslicht-mit-geringer-scharfentiefe-und-naturlichen-grunen-texturen-image691757577.htmlRF3C5C7RN–Nahaufnahme von Moos mit Sporenkapseln in einem Wald, aufgenommen bei weichem Tageslicht mit geringer Schärfentiefe und natürlichen grünen Texturen.
 In der Luft Pollenkorn, Heuschnupfen, Pollenallergie Stockfotohttps://www.alamy.de/image-license-details/?v=1https://www.alamy.de/stockfoto-in-der-luft-pollenkorn-heuschnupfen-pollenallergie-104210044.html
In der Luft Pollenkorn, Heuschnupfen, Pollenallergie Stockfotohttps://www.alamy.de/image-license-details/?v=1https://www.alamy.de/stockfoto-in-der-luft-pollenkorn-heuschnupfen-pollenallergie-104210044.htmlRFG1F4Y8–In der Luft Pollenkorn, Heuschnupfen, Pollenallergie
 Sporen auf der Unterseite eines Blattes Farn Stockfotohttps://www.alamy.de/image-license-details/?v=1https://www.alamy.de/stockfoto-sporen-auf-der-unterseite-eines-blattes-farn-58241014.html
Sporen auf der Unterseite eines Blattes Farn Stockfotohttps://www.alamy.de/image-license-details/?v=1https://www.alamy.de/stockfoto-sporen-auf-der-unterseite-eines-blattes-farn-58241014.htmlRFDAN306–Sporen auf der Unterseite eines Blattes Farn
 Schleimschimmelpilze sind eine Gruppe von Organismen, die sich über Sporen vermehren. Früher als Pilze klassifiziert, werden sie heute als Teil des Königreichs Protista betrachtet. Trotz ihrer unterschiedlichen Biologie weisen Schleimschimmelpilze ähnliche Eigenschaften auf, wie ihre Fähigkeit, Sporentragende Strukturen zu bilden. Stockfotohttps://www.alamy.de/image-license-details/?v=1https://www.alamy.de/stockfoto-schleimschimmelpilze-sind-eine-gruppe-von-organismen-die-sich-uber-sporen-vermehren-fruher-als-pilze-klassifiziert-werden-sie-heute-als-teil-des-konigreichs-protista-betrachtet-trotz-ihrer-unterschiedlichen-biologie-weisen-schleimschimmelpilze-ahnliche-eigenschaften-auf-wie-ihre-fahigkeit-sporentragende-strukturen-zu-bilden-129641398.html
Schleimschimmelpilze sind eine Gruppe von Organismen, die sich über Sporen vermehren. Früher als Pilze klassifiziert, werden sie heute als Teil des Königreichs Protista betrachtet. Trotz ihrer unterschiedlichen Biologie weisen Schleimschimmelpilze ähnliche Eigenschaften auf, wie ihre Fähigkeit, Sporentragende Strukturen zu bilden. Stockfotohttps://www.alamy.de/image-license-details/?v=1https://www.alamy.de/stockfoto-schleimschimmelpilze-sind-eine-gruppe-von-organismen-die-sich-uber-sporen-vermehren-fruher-als-pilze-klassifiziert-werden-sie-heute-als-teil-des-konigreichs-protista-betrachtet-trotz-ihrer-unterschiedlichen-biologie-weisen-schleimschimmelpilze-ahnliche-eigenschaften-auf-wie-ihre-fahigkeit-sporentragende-strukturen-zu-bilden-129641398.htmlRMHEWJWX–Schleimschimmelpilze sind eine Gruppe von Organismen, die sich über Sporen vermehren. Früher als Pilze klassifiziert, werden sie heute als Teil des Königreichs Protista betrachtet. Trotz ihrer unterschiedlichen Biologie weisen Schleimschimmelpilze ähnliche Eigenschaften auf, wie ihre Fähigkeit, Sporentragende Strukturen zu bilden.
 Fossile Baumfarne. Dieses Objekt ist Teil der Sammlung Bildung und Öffentlichkeitsarbeit, von denen einige im Q?rius Science Education Center sind und zu sehen sind.Paläozoikum - Karbon - Upper/Late214 Jan 2020Carbondale Stockfotohttps://www.alamy.de/image-license-details/?v=1https://www.alamy.de/fossile-baumfarne-dieses-objekt-ist-teil-der-sammlung-bildung-und-offentlichkeitsarbeit-von-denen-einige-im-qrius-science-education-center-sind-und-zu-sehen-sindpalaozoikum-karbon-upperlate214-jan-2020carbondale-image353463264.html
Fossile Baumfarne. Dieses Objekt ist Teil der Sammlung Bildung und Öffentlichkeitsarbeit, von denen einige im Q?rius Science Education Center sind und zu sehen sind.Paläozoikum - Karbon - Upper/Late214 Jan 2020Carbondale Stockfotohttps://www.alamy.de/image-license-details/?v=1https://www.alamy.de/fossile-baumfarne-dieses-objekt-ist-teil-der-sammlung-bildung-und-offentlichkeitsarbeit-von-denen-einige-im-qrius-science-education-center-sind-und-zu-sehen-sindpalaozoikum-karbon-upperlate214-jan-2020carbondale-image353463264.htmlRM2BF1J00–Fossile Baumfarne. Dieses Objekt ist Teil der Sammlung Bildung und Öffentlichkeitsarbeit, von denen einige im Q?rius Science Education Center sind und zu sehen sind.Paläozoikum - Karbon - Upper/Late214 Jan 2020Carbondale
 Kleiner Niststern (Geastrum quadrifidum) Stockfotohttps://www.alamy.de/image-license-details/?v=1https://www.alamy.de/kleiner-niststern-geastrum-quadrifidum-image680699200.html
Kleiner Niststern (Geastrum quadrifidum) Stockfotohttps://www.alamy.de/image-license-details/?v=1https://www.alamy.de/kleiner-niststern-geastrum-quadrifidum-image680699200.htmlRM3BFCENM–Kleiner Niststern (Geastrum quadrifidum)
 Bryum capillare im amazonaswald Stockfotohttps://www.alamy.de/image-license-details/?v=1https://www.alamy.de/bryum-capillare-im-amazonaswald-image621850539.html
Bryum capillare im amazonaswald Stockfotohttps://www.alamy.de/image-license-details/?v=1https://www.alamy.de/bryum-capillare-im-amazonaswald-image621850539.htmlRM2Y3KMKR–Bryum capillare im amazonaswald
 Pilze im Wald. Setas en el bosque. Stockfotohttps://www.alamy.de/image-license-details/?v=1https://www.alamy.de/pilze-im-wald-setas-en-el-bosque-image560811319.html
Pilze im Wald. Setas en el bosque. Stockfotohttps://www.alamy.de/image-license-details/?v=1https://www.alamy.de/pilze-im-wald-setas-en-el-bosque-image560811319.htmlRF2RGB4FK–Pilze im Wald. Setas en el bosque.
 Fliegende Samen sind botanische Strukturen, die für die Ausbreitung des Windes entwickelt wurden und es Pflanzen ermöglichen, sich durch natürliche Mechanismen zu vermehren und neue Gebiete zu kolonisieren. Stockfotohttps://www.alamy.de/image-license-details/?v=1https://www.alamy.de/stockfoto-fliegende-samen-sind-botanische-strukturen-die-fur-die-ausbreitung-des-windes-entwickelt-wurden-und-es-pflanzen-ermoglichen-sich-durch-naturliche-mechanismen-zu-vermehren-und-neue-gebiete-zu-kolonisieren-171513632.html
Fliegende Samen sind botanische Strukturen, die für die Ausbreitung des Windes entwickelt wurden und es Pflanzen ermöglichen, sich durch natürliche Mechanismen zu vermehren und neue Gebiete zu kolonisieren. Stockfotohttps://www.alamy.de/image-license-details/?v=1https://www.alamy.de/stockfoto-fliegende-samen-sind-botanische-strukturen-die-fur-die-ausbreitung-des-windes-entwickelt-wurden-und-es-pflanzen-ermoglichen-sich-durch-naturliche-mechanismen-zu-vermehren-und-neue-gebiete-zu-kolonisieren-171513632.htmlRMKY13AT–Fliegende Samen sind botanische Strukturen, die für die Ausbreitung des Windes entwickelt wurden und es Pflanzen ermöglichen, sich durch natürliche Mechanismen zu vermehren und neue Gebiete zu kolonisieren.
 Reif sporangien der Wand verschrauben - Moos (Tortula muralis) Wiltshire, UK, April. Stockfotohttps://www.alamy.de/image-license-details/?v=1https://www.alamy.de/reif-sporangien-der-wand-verschrauben-moos-tortula-muralis-wiltshire-uk-april-image263063053.html
Reif sporangien der Wand verschrauben - Moos (Tortula muralis) Wiltshire, UK, April. Stockfotohttps://www.alamy.de/image-license-details/?v=1https://www.alamy.de/reif-sporangien-der-wand-verschrauben-moos-tortula-muralis-wiltshire-uk-april-image263063053.htmlRMW7YFH1–Reif sporangien der Wand verschrauben - Moos (Tortula muralis) Wiltshire, UK, April.
 Spore Kapseln eines grünen Mooses, Pohlia nutans Stockfotohttps://www.alamy.de/image-license-details/?v=1https://www.alamy.de/spore-kapseln-eines-grunen-mooses-pohlia-nutans-image185133305.html
Spore Kapseln eines grünen Mooses, Pohlia nutans Stockfotohttps://www.alamy.de/image-license-details/?v=1https://www.alamy.de/spore-kapseln-eines-grunen-mooses-pohlia-nutans-image185133305.htmlRFMN5FBN–Spore Kapseln eines grünen Mooses, Pohlia nutans
 Sori mit Sporen auf Vogel's – Nest Fern (Asplenium Nidus) Stockfotohttps://www.alamy.de/image-license-details/?v=1https://www.alamy.de/stockfoto-sori-mit-sporen-auf-vogels-nest-fern-asplenium-nidus-83552141.html
Sori mit Sporen auf Vogel's – Nest Fern (Asplenium Nidus) Stockfotohttps://www.alamy.de/image-license-details/?v=1https://www.alamy.de/stockfoto-sori-mit-sporen-auf-vogels-nest-fern-asplenium-nidus-83552141.htmlRFERX3H1–Sori mit Sporen auf Vogel's – Nest Fern (Asplenium Nidus)
 Pilzartige Fruchtkörper, Abbildung Stockfotohttps://www.alamy.de/image-license-details/?v=1https://www.alamy.de/pilzartige-fruchtkorper-abbildung-image332250577.html
Pilzartige Fruchtkörper, Abbildung Stockfotohttps://www.alamy.de/image-license-details/?v=1https://www.alamy.de/pilzartige-fruchtkorper-abbildung-image332250577.htmlRF2A8F901–Pilzartige Fruchtkörper, Abbildung
 Nahaufnahme auf der Rückseite einer Farn Blatt mit spore Stockfotohttps://www.alamy.de/image-license-details/?v=1https://www.alamy.de/nahaufnahme-auf-der-ruckseite-einer-farn-blatt-mit-spore-image265925380.html
Nahaufnahme auf der Rückseite einer Farn Blatt mit spore Stockfotohttps://www.alamy.de/image-license-details/?v=1https://www.alamy.de/nahaufnahme-auf-der-ruckseite-einer-farn-blatt-mit-spore-image265925380.htmlRFWCHXF0–Nahaufnahme auf der Rückseite einer Farn Blatt mit spore
 Der fruchtbare Sporenschaft eines Horsetailfarns, Gattung Equisetum, im April. Die Gattung Equisetum ist in der Pflanzenwelt einzigartig, da sie usi reproduzieren Stockfotohttps://www.alamy.de/image-license-details/?v=1https://www.alamy.de/der-fruchtbare-sporenschaft-eines-horsetailfarns-gattung-equisetum-im-april-die-gattung-equisetum-ist-in-der-pflanzenwelt-einzigartig-da-sie-usi-reproduzieren-image352265035.html
Der fruchtbare Sporenschaft eines Horsetailfarns, Gattung Equisetum, im April. Die Gattung Equisetum ist in der Pflanzenwelt einzigartig, da sie usi reproduzieren Stockfotohttps://www.alamy.de/image-license-details/?v=1https://www.alamy.de/der-fruchtbare-sporenschaft-eines-horsetailfarns-gattung-equisetum-im-april-die-gattung-equisetum-ist-in-der-pflanzenwelt-einzigartig-da-sie-usi-reproduzieren-image352265035.htmlRM2BD31J3–Der fruchtbare Sporenschaft eines Horsetailfarns, Gattung Equisetum, im April. Die Gattung Equisetum ist in der Pflanzenwelt einzigartig, da sie usi reproduzieren
Schimmel im Orangensaft Makro Bild Stockfotohttps://www.alamy.de/image-license-details/?v=1https://www.alamy.de/stockfoto-schimmel-im-orangensaft-makro-bild-101726421.html
Schimmel im Orangensaft Makro Bild Stockfotohttps://www.alamy.de/image-license-details/?v=1https://www.alamy.de/stockfoto-schimmel-im-orangensaft-makro-bild-101726421.htmlRFFWE12D–Schimmel im Orangensaft Makro Bild
 Sporangie auf Farn. Sporanges-Gruppen auf Farnblättern. Reproduktion von Polypodiopsida oder Polypodiophyta. Schönheit in der Natur. Stockfotohttps://www.alamy.de/image-license-details/?v=1https://www.alamy.de/sporangie-auf-farn-sporanges-gruppen-auf-farnblattern-reproduktion-von-polypodiopsida-oder-polypodiophyta-schonheit-in-der-natur-image467020171.html
Sporangie auf Farn. Sporanges-Gruppen auf Farnblättern. Reproduktion von Polypodiopsida oder Polypodiophyta. Schönheit in der Natur. Stockfotohttps://www.alamy.de/image-license-details/?v=1https://www.alamy.de/sporangie-auf-farn-sporanges-gruppen-auf-farnblattern-reproduktion-von-polypodiopsida-oder-polypodiophyta-schonheit-in-der-natur-image467020171.htmlRF2J3PGYR–Sporangie auf Farn. Sporanges-Gruppen auf Farnblättern. Reproduktion von Polypodiopsida oder Polypodiophyta. Schönheit in der Natur.
 Sporen in der sporangien auf der Unterseite der Wedel von dicksonia Antarctica, Hardy immergrüner Baum Farn Stockfotohttps://www.alamy.de/image-license-details/?v=1https://www.alamy.de/sporen-in-der-sporangien-auf-der-unterseite-der-wedel-von-dicksonia-antarctica-hardy-immergruner-baum-farn-image159210956.html
Sporen in der sporangien auf der Unterseite der Wedel von dicksonia Antarctica, Hardy immergrüner Baum Farn Stockfotohttps://www.alamy.de/image-license-details/?v=1https://www.alamy.de/sporen-in-der-sporangien-auf-der-unterseite-der-wedel-von-dicksonia-antarctica-hardy-immergruner-baum-farn-image159210956.htmlRMK70K5G–Sporen in der sporangien auf der Unterseite der Wedel von dicksonia Antarctica, Hardy immergrüner Baum Farn
 Nahaufnahme des Sporophytenstadiums der Moospflanzen - Pisgah National Forest, nahe Brevard, North Carolina, USA Stockfotohttps://www.alamy.de/image-license-details/?v=1https://www.alamy.de/nahaufnahme-des-sporophytenstadiums-der-moospflanzen-pisgah-national-forest-nahe-brevard-north-carolina-usa-image601339048.html
Nahaufnahme des Sporophytenstadiums der Moospflanzen - Pisgah National Forest, nahe Brevard, North Carolina, USA Stockfotohttps://www.alamy.de/image-license-details/?v=1https://www.alamy.de/nahaufnahme-des-sporophytenstadiums-der-moospflanzen-pisgah-national-forest-nahe-brevard-north-carolina-usa-image601339048.htmlRM2WX9A2G–Nahaufnahme des Sporophytenstadiums der Moospflanzen - Pisgah National Forest, nahe Brevard, North Carolina, USA
 Sporen der Königsfarn Osmunda Regalis auf fruchtbaren Wedel Roudsea Wald Natur Reserve Cumbria Juni Stockfotohttps://www.alamy.de/image-license-details/?v=1https://www.alamy.de/stockfoto-sporen-der-konigsfarn-osmunda-regalis-auf-fruchtbaren-wedel-roudsea-wald-natur-reserve-cumbria-juni-15387076.html
Sporen der Königsfarn Osmunda Regalis auf fruchtbaren Wedel Roudsea Wald Natur Reserve Cumbria Juni Stockfotohttps://www.alamy.de/image-license-details/?v=1https://www.alamy.de/stockfoto-sporen-der-konigsfarn-osmunda-regalis-auf-fruchtbaren-wedel-roudsea-wald-natur-reserve-cumbria-juni-15387076.htmlRMAN25FH–Sporen der Königsfarn Osmunda Regalis auf fruchtbaren Wedel Roudsea Wald Natur Reserve Cumbria Juni
 Pollenkörner auf Blume, Heuschnupfen, Pollenallergie Stockfotohttps://www.alamy.de/image-license-details/?v=1https://www.alamy.de/stockfoto-pollenkorner-auf-blume-heuschnupfen-pollenallergie-104210042.html
Pollenkörner auf Blume, Heuschnupfen, Pollenallergie Stockfotohttps://www.alamy.de/image-license-details/?v=1https://www.alamy.de/stockfoto-pollenkorner-auf-blume-heuschnupfen-pollenallergie-104210042.htmlRFG1F4Y6–Pollenkörner auf Blume, Heuschnupfen, Pollenallergie
 Sporen auf der Unterseite eines Blattes Farn Stockfotohttps://www.alamy.de/image-license-details/?v=1https://www.alamy.de/stockfoto-sporen-auf-der-unterseite-eines-blattes-farn-58240299.html
Sporen auf der Unterseite eines Blattes Farn Stockfotohttps://www.alamy.de/image-license-details/?v=1https://www.alamy.de/stockfoto-sporen-auf-der-unterseite-eines-blattes-farn-58240299.htmlRMDAN22K–Sporen auf der Unterseite eines Blattes Farn
 Anthurus archeri, auch bekannt als Stinkhornpilz, tritt aus dem Boden als eine einzigartige eiartige Struktur hervor. Es setzt einen übel riechenden Schleim frei, der Fliegen anzieht, was bei der Verteilung seiner Sporen hilft und eine entscheidende Rolle bei der Fortpflanzung spielt. Stockfotohttps://www.alamy.de/image-license-details/?v=1https://www.alamy.de/stockfoto-anthurus-archeri-auch-bekannt-als-stinkhornpilz-tritt-aus-dem-boden-als-eine-einzigartige-eiartige-struktur-hervor-es-setzt-einen-ubel-riechenden-schleim-frei-der-fliegen-anzieht-was-bei-der-verteilung-seiner-sporen-hilft-und-eine-entscheidende-rolle-bei-der-fortpflanzung-spielt-129643107.html
Anthurus archeri, auch bekannt als Stinkhornpilz, tritt aus dem Boden als eine einzigartige eiartige Struktur hervor. Es setzt einen übel riechenden Schleim frei, der Fliegen anzieht, was bei der Verteilung seiner Sporen hilft und eine entscheidende Rolle bei der Fortpflanzung spielt. Stockfotohttps://www.alamy.de/image-license-details/?v=1https://www.alamy.de/stockfoto-anthurus-archeri-auch-bekannt-als-stinkhornpilz-tritt-aus-dem-boden-als-eine-einzigartige-eiartige-struktur-hervor-es-setzt-einen-ubel-riechenden-schleim-frei-der-fliegen-anzieht-was-bei-der-verteilung-seiner-sporen-hilft-und-eine-entscheidende-rolle-bei-der-fortpflanzung-spielt-129643107.htmlRMHEWN2Y–Anthurus archeri, auch bekannt als Stinkhornpilz, tritt aus dem Boden als eine einzigartige eiartige Struktur hervor. Es setzt einen übel riechenden Schleim frei, der Fliegen anzieht, was bei der Verteilung seiner Sporen hilft und eine entscheidende Rolle bei der Fortpflanzung spielt.
 Lycopodium clavatum L Lycopodium clavatum L. Stockfotohttps://www.alamy.de/image-license-details/?v=1https://www.alamy.de/lycopodium-clavatum-l-lycopodium-clavatum-l-image360507063.html
Lycopodium clavatum L Lycopodium clavatum L. Stockfotohttps://www.alamy.de/image-license-details/?v=1https://www.alamy.de/lycopodium-clavatum-l-lycopodium-clavatum-l-image360507063.htmlRM2BXEEC7–Lycopodium clavatum L Lycopodium clavatum L.
 Haubenzinkung (Coprinus comatus) Stockfotohttps://www.alamy.de/image-license-details/?v=1https://www.alamy.de/haubenzinkung-coprinus-comatus-image680669212.html
Haubenzinkung (Coprinus comatus) Stockfotohttps://www.alamy.de/image-license-details/?v=1https://www.alamy.de/haubenzinkung-coprinus-comatus-image680669212.htmlRM3BFB4EM–Haubenzinkung (Coprinus comatus)
 Ein neues grünes Farnblatt voller kleiner gelber Sporenbälle. Selektive Fokussierung, Bereiche außerhalb des Fokus. Stockfotohttps://www.alamy.de/image-license-details/?v=1https://www.alamy.de/ein-neues-grunes-farnblatt-voller-kleiner-gelber-sporenballe-selektive-fokussierung-bereiche-ausserhalb-des-fokus-image551998702.html
Ein neues grünes Farnblatt voller kleiner gelber Sporenbälle. Selektive Fokussierung, Bereiche außerhalb des Fokus. Stockfotohttps://www.alamy.de/image-license-details/?v=1https://www.alamy.de/ein-neues-grunes-farnblatt-voller-kleiner-gelber-sporenballe-selektive-fokussierung-bereiche-ausserhalb-des-fokus-image551998702.htmlRF2R21KYA–Ein neues grünes Farnblatt voller kleiner gelber Sporenbälle. Selektive Fokussierung, Bereiche außerhalb des Fokus.
 Collared earthstar, eine Art puffball, lösen eine Wolke von Sporen Stockfotohttps://www.alamy.de/image-license-details/?v=1https://www.alamy.de/collared-earthstar-eine-art-puffball-losen-eine-wolke-von-sporen-image381527416.html
Collared earthstar, eine Art puffball, lösen eine Wolke von Sporen Stockfotohttps://www.alamy.de/image-license-details/?v=1https://www.alamy.de/collared-earthstar-eine-art-puffball-losen-eine-wolke-von-sporen-image381527416.htmlRF2D4M234–Collared earthstar, eine Art puffball, lösen eine Wolke von Sporen